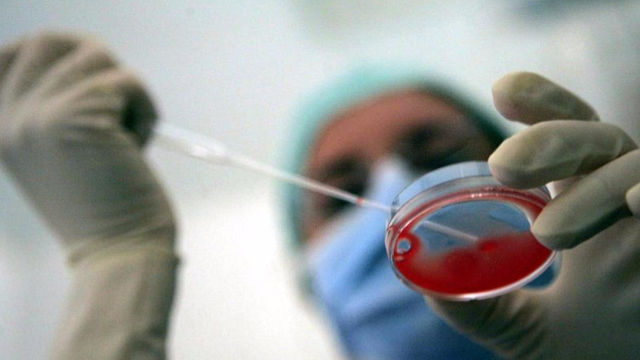

Ottenuto il primo lievito che ha circa il 50% del Dna sintetico, con cromosomi costruiti in laboratorio. Descritto in una serie di articoli pubblicati sulle riviste Cell, Molecular Cell e Cell Genomics, è stato ottenuto dal progetto internazionale Synthetic Yeast Genome Project.
Un risultato che ha una portata rivoluzionaria sia per la ricerca, in quanto aiuterà a capire meglio il Dna naturale, sia per le possibili applicazioni in molti campi, dall'industria alla biomedicina, "dalla creazione di nuovi ceppi microbici per una bioproduzione più verde, fino ad aiutarci a comprendere e combattere le malattie", osserva uno degli autori della ricerca, Ben Blount dell’Università britannica di Nottingham. Dopo i primi virus e batteri progettati in laboratorio, la biologia sintetica è ora riuscita a integrare grandi quantità di Dna sintetico in un eucariota, ossia in un organismo più complesso e con cellule dotate di nucleo. Il lavoro, frutto di 10 anni di studi, ha permesso per la prima volta di produrre da zero il genoma di un eucariota, il dominio della vita di cui fanno parte anche i mammiferi, riuscendo a ottenere lieviti capaci di vivere e riprodursi avendo al loro interno ben 8 cromosomi artificiali su 16. Un successo che viene definito come una pietra miliare per la biologia sintetica. "Anche se da tempo siamo in grado di modificare i geni, non eravamo mai stati in grado di scrivere da zero il genoma di un eucariota. Questo lavoro è fondamentale per la nostra comprensione degli elementi costitutivi della vita e ha il potenziale per rivoluzionare la biologia sintetica", ha detto Patrick Cai, esperto di Genomica sintetica dell’università di Manchester.